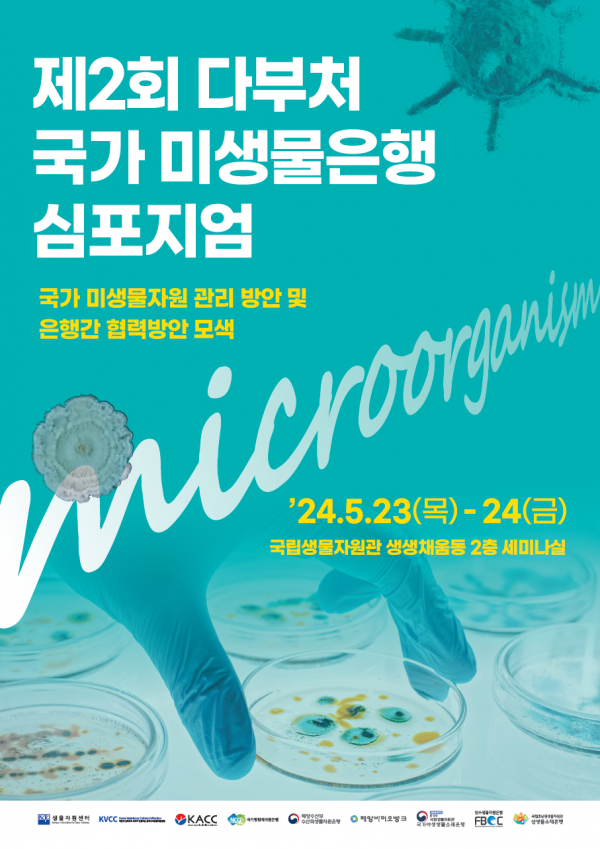

[아시아월드뉴스] 환경부 소속 국립생물자원관은 5월 23일부터 이틀간 국립생물자원관 생생채움동 2층 세미나실에서 ʻ제2회 다부처 국가 미생물은행 학술교류회ʼ를 개최한다고 밝혔다.
이번 교류회는 여러 바이오소재 클러스터에 나뉘어 있는 미생물은행의 표준 운영 방안을 정립하고 미생물 소재의 안정적 보존 및 활용 촉진 방안을 논의하기 위해 마련됐다.
교류회는 6개 부처 소속의 9개 미생물은행이 참여하며 △국내 미생물 소재의 해외 분양 현황, △산업용 미생물 분양 현황, △이익공유 사례를 공유한다.
또한, 범부처 바이오소재 클러스터 총괄지원단과 함께 미생물 소재의 산업적 활용을 위한 범정부 차원의 지침도 논의한다.
서민환 국립생물자원관장은 “최근 식품, 의약품 등 다양한 분야에서 미생물을 사용하려는 기업이 늘고 있지만 관련 정보 부족으로 어려움을 호소하고 있다”며 “국가 미생물은행에서 보유한 미생물 소재자원을 다양한 기업들이 쉽게 활용할 수 있도록 적극적으로 지원하겠다”고 밝혔다.
저작권자 © 아시아월드뉴스 무단전재 및 재배포 금지

